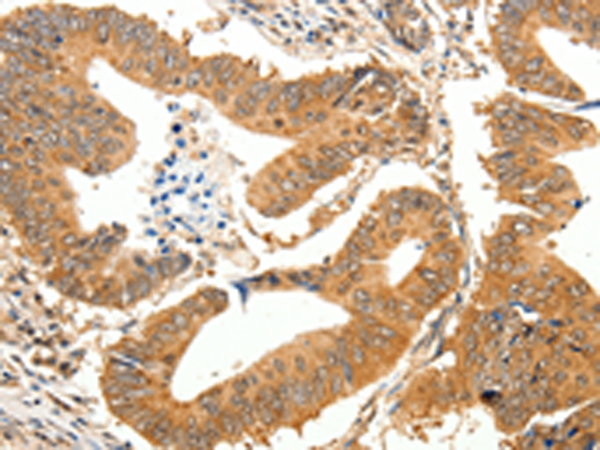

-
分类: 科研抗体货号: P11379别名: ODZ3; TNM3; Ten-m3应用: IHC反应种属: Human, Mouse
-
分类: 科研抗体货号: P11353别名: NHE7; NHE-7; SLC9A6应用: IHC反应种属: Human, Mouse
-
分类: 科研抗体货号: P11377别名: TN-R应用: IHC反应种属: Human, Mouse, Rat
-
分类: 科研抗体货号: P11352别名: AT1, AT-1, ACATN, SPG42, CCHLND应用: WB反应种属: Human, Mouse, Rat
-
分类: 科研抗体货号: P11376别名: TN-W应用: IHC反应种属: Human, Mouse
-
分类: 科研抗体货号: P11351别名: VGAT, VIAAT应用: WB,IHC反应种属: Human, Mouse, Rat
-
分类: 科研抗体货号: P11375别名: GAD; SCP; CPSQ1应用: WB,IHC反应种属: Human, Mouse, Rat
-
分类: 科研抗体货号: P11350别名: FATP; FATP1; ACSVL5应用: IHC反应种属: Human
-
分类: 科研抗体货号: P11374别名: MAP5; FUTSCH应用: IHC反应种属: Human, Mouse, Rat
-
分类: 科研抗体货号: P11349别名: NCKX; RODX; NCKX1; CSNB1D; HsT17412应用: WB反应种属: Human, Rat

鄂公网安备42018502007531号
鄂公网安备42018502007531号

